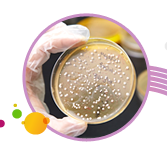

- Lactobacillus acidophilus 嗜酸乳桿菌
- Lactobacillus casei 乾酪乳桿菌
- Lactobacillus helveticus 瑞士乳桿菌
- Lactobacillus paracasei 副乾酪乳桿菌
- Lactobacillus plantarum 植物乳桿菌
- Lactobacillus reuteri 羅伊氏乳桿菌
- Lactobacillus rhamnosus 鼠李糖乳桿菌
- Lactobacillus salivarius 唾液乳桿菌
- Lactobacillus gasseri 加氏乳桿菌
- Lactobacillus johnsonii 約氏乳桿菌